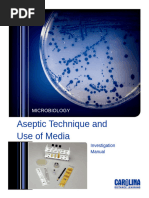

C4 carbon fixation or the Hatch–Slack pathway is one of three known photosynthetic processes
of carbon fixation in plants. It owes the names to the 1960's discovery by Marshall Davidson
Hatch and Charles Roger Slack[1] that some plants, when supplied with 14CO2, incorporate the 14C
label into four-carbon molecules first.
C4 fixation is an addition to the ancestral and more common C3 carbon fixation. The main
carboxylating enzyme in C3 photosynthesis is called RuBisCO, which catalyses two distinct
reactions using either CO2 (carboxylation) or oxygen (oxygenation) as a substrate. The latter
process, oxygenation, gives rise to the wasteful process of photorespiration. C4 photosynthesis
reduces photorespiration by concentrating CO2 around RuBisCO. To ensure that RuBisCO works
in an environment where there is a lot of carbon dioxide and very little oxygen, C4 leaves
generally differentiate two partially isolated compartments called mesophyll cells and bundle-
sheath cells. CO2 is initially fixed in the mesophyll cells by the enzyme PEP carboxylase which
reacts the three carbon phosphoenolpyruvate (PEP) with CO2 to form the four carbon oxaloacetic
acid (OAA). OAA can be chemically reduced to malate or transaminated to aspartate. These
intermediates diffuse to the bundle sheath cells, where they are decarboxylated, creating a CO2-
rich environment around RuBisCO and thereby suppressing photorespiration. The resulting
pyruvate (PYR), together with about half of the phosphoglycerate (PGA) produced by RuBisCO,
diffuses back to the mesophyll. PGA is then chemically reduced and diffuses back to the bundle
sheath to complete the reductive pentose phosphate cycle (RPP). This exchange of metabolites is
essential for C4 photosynthesis to work.
On one hand, these additional steps require more energy in the form of ATP to regenerate PEP.
On the other hand, concentrating CO2 allows high rates of photosynthesis at higher temperatures.
Higher concentration overcomes the reduction of gas solubility with temperature (Henry's law).
The CO2 concentrating mechanism also maintains high gradients of CO2 concentration across the
stomatal pores. This means that C4 plants have generally lower stomatal conductance, reduced
water losses and have generally higher water-use efficiency.[2] C4 plants are also more efficient in
using nitrogen, since PEP carboxylase is much cheaper to make than RuBisCO.[3] However, since
the C3 pathway does not require extra energy for the regeneration of PEP, it is more efficient in
conditions where photorespiration is limited, typically at low temperatures and in the shade.[4]
Discovery
The first experiments indicating that some plants do not use C3 carbon fixation but instead
produce malate and aspartate in the first step of carbon fixation were done in the 1950s and early
1960s by Hugo Peter Kortschak and Yuri Karpilov.[5][6] The C4 pathway was elucidated by
Marshall Davidson Hatch and Charles Roger Slack, in Australia, in 1966.[1] While Hatch and
Slack originally referred to the pathway as the "C4 dicarboxylic acid pathway", it is sometimes
called the Hatch–Slack pathway.[6]
Anatomy
�Cross section of a maize leaf, a C4 plant. Kranz anatomy (rings of cells) shown
C4 plants often possess a characteristic leaf anatomy called kranz anatomy, from the German
word for wreath. Their vascular bundles are surrounded by two rings of cells; the inner ring,
called bundle sheath cells, contains starch-rich chloroplasts lacking grana, which differ from
those in mesophyll cells present as the outer ring. Hence, the chloroplasts are called dimorphic.
The primary function of kranz anatomy is to provide a site in which CO2 can be concentrated
around RuBisCO, thereby avoiding photorespiration. Mesophyll and bundle sheath cells are
connected through numerous cytoplasmic sleeves called plasmodesmata whose permeability at
leaf level is called bundle sheath conductance. A layer of suberin[7] is often deposed at the level
of the middle lamella (tangential interface between mesophyll and bundle sheath) in order to
reduce the apoplastic diffusion of CO2 (called leakage). The carbon concentration mechanism in
C4 plants distinguishes their isotopic signature from other photosynthetic organisms.
Although most C4 plants exhibit kranz anatomy, there are, however, a few species that operate a
limited C4 cycle without any distinct bundle sheath tissue. Suaeda aralocaspica, Bienertia
cycloptera, Bienertia sinuspersici and Bienertia kavirense (all chenopods) are terrestrial plants
that inhabit dry, salty depressions in the deserts of the Middle East. These plants have been
shown to operate single-cell C4 CO2-concentrating mechanisms, which are unique among the
known C4 mechanisms.[8][9][10][11] Although the cytology of both genera differs slightly, the basic
principle is that fluid-filled vacuoles are employed to divide the cell into two separate areas.
Carboxylation enzymes in the cytosol are separated from decarboxylase enzymes and RuBisCO
in the chloroplasts. A diffusive barrier is between the chloroplasts (which contain RuBisCO) and
the cytosol. This enables a bundle-sheath-type area and a mesophyll-type area to be established
within a single cell. Although this does allow a limited C4 cycle to operate, it is relatively
inefficient. Much leakage of CO2 from around RuBisCO occurs.
There is also evidence of inducible C4 photosynthesis by non-kranz aquatic macrophyte Hydrilla
verticillata under warm conditions, although the mechanism by which CO2 leakage from around
RuBisCO is minimised is currently uncertain.[12]
Biochemistry
�In C3 plants, the first step in the light-independent reactions of photosynthesis is the fixation of
CO2 by the enzyme RuBisCO to form 3-phosphoglycerate. However, RuBisCo has a dual
carboxylase and oxygenase activity. Oxygenation results in part of the substrate being oxidized
rather than carboxylated, resulting in loss of substrate and consumption of energy, in what is
known as photorespiration. Oxygenation and carboxylation are competitive, meaning that the
rate of the reactions depends on the relative concentration of oxygen and CO2.
In order to reduce the rate of photorespiration, C4 plants increase the concentration of CO2
around RuBisCO. To do so two partially isolated compartments differentiate within leaves, the
mesophyll and the bundle sheath. Instead of direct fixation by RuBisCO, CO2 is initially
incorporated into a four-carbon organic acid (either malate or aspartate) in the mesophyll. The
organic acids then diffuse through plasmodesmata into the bundle sheath cells. There, they are
decarboxylated creating a CO2-rich environment. The chloroplasts of the bundle sheath cells
convert this CO2 into carbohydrates by the conventional C3 pathway.
There is large variability in the biochemical features of C4 assimilation, and it is generally
grouped in three subtypes, differentiated by the main enzyme used for decarboxylation ( NADP-
malic enzyme, NADP-ME; NAD-malic enzyme, NAD-ME; and PEP carboxykinase, PEPCK).
Since PEPCK is often recruited atop NADP-ME or NAD-ME it was proposed to classify the
biochemical variability in two subtypes. For instance, maize and sugarcane use a combination of
NADP-ME and PEPCK, millet uses preferentially NAD-ME and Megathyrsus maximus, uses
preferentially PEPCK.
NADP-ME
NADP-ME subtype
The first step in the NADP-ME type C4 pathway is the conversion of pyruvate (Pyr) to
phosphoenolpyruvate (PEP), by the enzyme Pyruvate phosphate dikinase (PPDK). This reaction
requires inorganic phosphate and ATP plus pyruvate, producing PEP, AMP, and inorganic
pyrophosphate (PPi). The next step is the carboxylation of PEP by the PEP carboxylase enzyme
(PEPC) producing oxaloacetate. Both of these steps occur in the mesophyll cells:
pyruvate + Pi + ATP → PEP + AMP + PPi
PEP + CO2 → oxaloacetate
PEPC has a low KM for HCO−
3 — and, hence, high affinity, and is not confounded by O2 thus it will work even at low
concentrations of CO2.
�The product is usually converted to malate (M), which diffuses to the bundle-sheath cells
surrounding a nearby vein. Here, it is decarboxylated by the NADP-malic enzyme (NADP-ME)
to produce CO2 and pyruvate. The CO2 is fixed by RuBisCo to produce phosphoglycerate (PGA)
while the pyruvate is transported back to the mesophyll cell, together with about half of the
phosphoglycerate (PGA). This PGA is chemically reduced in the mesophyll and diffuses back to
the bundle sheath where it enters the conversion phase of the Calvin cycle. For each CO2
molecule exported to the bundle sheath the malate shuttle transfers two electrons, and therefore
reduces the demand of reducing power in the bundle sheath.
NAD-ME
NAD-ME subtype
Here, the OAA produced by PEPC is transaminated by aspartate aminotransferase to aspartate
(ASP) which is the metabolite diffusing to the bundle sheath. In the bundle sheath ASP is
transaminated again to OAA and then undergoes a futile reduction and oxidative decarboxylation
to release CO2. The resulting Pyruvate is transaminated to alanine, diffusing to the mesophyll.
Alanine is finally transaminated to pyruvate (PYR) which can be regenerated to PEP by PPDK in
the mesophyll chloroplasts. This cycle bypasses the reaction of malate dehydrogenase in the
mesophyll and therefore does not transfer reducing equivalents to the bundle sheath.
PEPCK
PEPCK subtype
In this variant the OAA produced by aspartate aminotransferase in the bundle sheath is
decarboxylated to PEP by PEPCK. The fate of PEP is still debated. The simplest explanation is
�that PEP would diffuse back to the mesophyll to serve as a substrate for PEPC. Because PEPCK
uses only one ATP molecule, the regeneration of PEP through PEPCK would theoretically
increase photosynthetic efficiency of this subtype, however this has never been measured. An
increase in relative expression of PEPCK has been observed under low light, and it has been
proposed to play a role in facilitating balancing energy requirements between mesophyll and
bundle sheath.
Metabolite exchange
While in C3 photosynthesis each chloroplast is capable of completing light reactions and dark
reactions, C4 chloroplasts differentiate in two populations, contained in the mesophyll and bundle
sheath cells. The division of the photosynthetic work between two types of chloroplasts results
inevitably in a prolific exchange of intermediates between them. The fluxes are large and can be
up to ten times the rate of gross assimilation.[13] The type of metabolite exchanged and the overall
rate will depend on the subtype. To reduce product inhibition of photosynthetic enzymes (for
instance PECP) concentration gradients need to be as low as possible. This requires increasing
the conductance of metabolites between mesophyll and bundle sheath, but this would also
increase the retrodiffusion of CO2 out of the bundle sheath, resulting in an inherent and inevitable
trade off in the optimisation of the CO2 concentrating mechanism.
Light harvesting and light reactions
To meet the NADPH and ATP demands in the mesophyll and bundle sheath, light needs to be
harvested and shared between two distinct electron transfer chains. ATP may be produced in the
bundle sheath mainly through cyclic electron flow around Photosystem I, or in the M mainly
through linear electron flow depending on the light available in the bundle sheath or in the
mesophyll. The relative requirement of ATP and NADPH in each type of cells will depend on
the photosynthetic subtype.[13] The apportioning of excitation energy between the two cell types
will influence the availability of ATP and NADPH in the mesohyll and bundle sheath. For
instance, green light is not strongly adsorbed by mesophyll cells and can preferentially excite
bundle sheath cells, or vice versa for blue light.[14] Because bundle sheaths are surrounded by
mesophyll, light harvesting in the mesophyll will reduce the light available to reach BS cells.
Also, the bundle sheath size limits the amount of light that can be harvested.[15]
Efficiency
Different formulations of efficiency are possible depending on which outputs and inputs are
considered. For instance, average quantum efficiency is the ratio between gross assimilation and
either absorbed or incident light intensity. Large variability of measured quantum efficiency is
reported in the literature between plants grown in different conditions and classified in different
subtypes but the underpinnings are still unclear. One of the components of quantum efficiency is
the efficiency of dark reactions, biochemical efficiency, which is generally expressed in
reciprocal terms as ATP cost of gross assimilation (ATP/GA). In C3 photosynthesis ATP/GA
depends mainly on CO2 and O2 concentration at the carboxylating sites of RuBisCO. When CO2
concentration is high and O2 concentration is low photorespiration is suppressed and C3
�assimilation is fast and efficient, with ATP/GA approaching the theoretical minimum of 3. In C4
photosynthesis CO2 concentration at the RuBisCO carboxylating sites is mainly the result of the
operation of the CO2 concentrating mechanisms, which cost circa an additional 2 ATP/GA but
makes efficiency relatively insensitive of external CO2 concentration in a broad range of
conditions. Biochemical efficiency depends mainly on the speed of CO2 delivery to the bundle
sheath, and will generally decrease under low light when PEP carboxylation rate decreases,
lowering the ratio of CO2/O2 concentration at the carboxylating sites of RuBisCO. The key
parameter defining how much efficiency will decrease under low light is bundle sheath
conductance. Plants with higher bundle sheath conductance will be facilitated in the exchange of
metabolites between the mesophyll and bundle sheath and will be capable of high rates of
assimilation under high light. However, they will also have high rates of CO2 retrodiffusion from
the bundle sheath (called leakage) which will increase photorespiration and decrease biochemical
efficiency under dim light. This represents an inherent and inevitable trade off in the operation of
C4 photosynthesis. C4 plants have an outstanding capacity to attune bundle sheath conductance.
Interestingly, bundle sheath conductance is downregulated in plants grown under low light[16] and
in plants grown under high light subsequently transferred to low light as it occurs in crop
canopies where older leaves are shaded by new growth.[17]
Evolution and advantages
Further information: Evolutionary history of plants § Evolution of photosynthetic pathways
C4 plants have a competitive advantage over plants possessing the more common C3 carbon
fixation pathway under conditions of drought, high temperatures, and nitrogen or CO2 limitation.
When grown in the same environment, at 30 °C, C3 grasses lose approximately 833 molecules of
water per CO2 molecule that is fixed, whereas C4 grasses lose only 277. This increased water use
efficiency of C4 grasses means that soil moisture is conserved, allowing them to grow for longer
in arid environments.[18]
C4 carbon fixation has evolved in up to 61 independent occasions in 19 different families of
plants, making it a prime example of convergent evolution.[19] This convergence may have been
facilitated by the fact that many potential evolutionary pathways to a C4 phenotype exist, many
of which involve initial evolutionary steps not directly related to photosynthesis.[20] C4 plants
arose around 35 million years ago[19] during the Oligocene (precisely when is difficult to
determine) and did not become ecologically significant until around 6 to 7 million years ago, in
the Miocene.[21] C4 metabolism in grasses originated when their habitat migrated from the shady
forest undercanopy to more open environments,[22] where the high sunlight gave it an advantage
over the C3 pathway.[23] Drought was not necessary for its innovation; rather, the increased
parsimony in water use was a byproduct of the pathway and allowed C4 plants to more readily
colonize arid environments.[23]
Today, C4 plants represent about 5% of Earth's plant biomass and 3% of its known plant species.
[18][24]
Despite this scarcity, they account for about 23% of terrestrial carbon fixation.[21][25]
Increasing the proportion of C4 plants on earth could assist biosequestration of CO2 and represent
an important climate change avoidance strategy. Present-day C4 plants are concentrated in the
�tropics and subtropics (below latitudes of 45 degrees) where the high air temperature increases
rates of photorespiration in C3 plants.
Plants that use C4 carbon fixation
See also: List of C4 plants
About 8,100 plant species use C4 carbon fixation, which represents about 3% of all terrestrial
species of plants.[25][26] All these 8,100 species are angiosperms. C4 carbon fixation is more
common in monocots compared with dicots, with 40% of monocots using the C4 pathway[clarification
needed]
, compared with only 4.5% of dicots. Despite this, only three families of monocots use C4
carbon fixation compared to 15 dicot families. Of the monocot clades containing C4 plants, the
grass (Poaceae) species use the C4 photosynthetic pathway most. 46% of grasses are C4 and
together account for 61% of C4 species. C4 has arisen independently in the grass family some
twenty or more times, in various subfamilies, tribes, and genera,[27] including the Andropogoneae
tribe which contains the food crops maize, sugar cane, and sorghum. Various kinds of millet are
also C4.[28][29] Of the dicot clades containing C4 species, the order Caryophyllales contains the
most species. Of the families in the Caryophyllales, the Chenopodiaceae use C4 carbon fixation
the most, with 550 out of 1,400 species using it. About 250 of the 1,000 species of the related
Amaranthaceae also use C4.[18][30]
Members of the sedge family Cyperaceae, and members of numerous families of eudicots –
including Asteraceae (the daisy family), Brassicaceae (the cabbage family), and Euphorbiaceae
(the spurge family) – also use C4.
There are very few trees which use C4. Only a handful are known: Paulownia, seven Hawaiian
Euphorbia species and a few desert shrubs that reach the size and shape of trees with age.[31][32]
Converting C3 plants to C4
Given the advantages of C4, a group of scientists from institutions around the world are working
on the C4 Rice Project to produce a strain of rice, naturally a C3 plant, that uses the C4 pathway
by studying the C4 plants maize and Brachypodium.[33] As rice is the world's most important
human food—it is the staple food for more than half the planet—having rice that is more
efficient at converting sunlight into grain could have significant global benefits towards
improving food security. The team claim C4 rice could produce up to 50% more grain—and be
able to do it with less water and nutrients.[34][35][36]
The researchers have already identified genes needed for C4 photosynthesis in rice and are now
looking towards developing a prototype C4 rice plant. In 2012, the Government of the United
Kingdom along with the Bill & Melinda Gates Foundation provided US$14 million over three
years towards the C4 Rice Project at the International Rice Research Institute.[37] In 2019, the Bill
& Melinda Gates Foundation granted another US$15 million to the Oxford-University-led C4
Rice Project. The goal of the 5-year project is to have experimental field plots up and running in
Taiwan by 2024.[38]
�C2 photosynthesis, an intermediate step between C3 and Kranz C4, may be preferred over C4 for
rice conversion. The simpler system is less optimized for high light and high temperature
conditions than C4, but has the advantage of requiring fewer steps of genetic engineering and
performing better under than C3 under all temperatures and light levels.[39] In 2021, the UK
Government provided GB£1.2 million on studying C2 engineering.[4